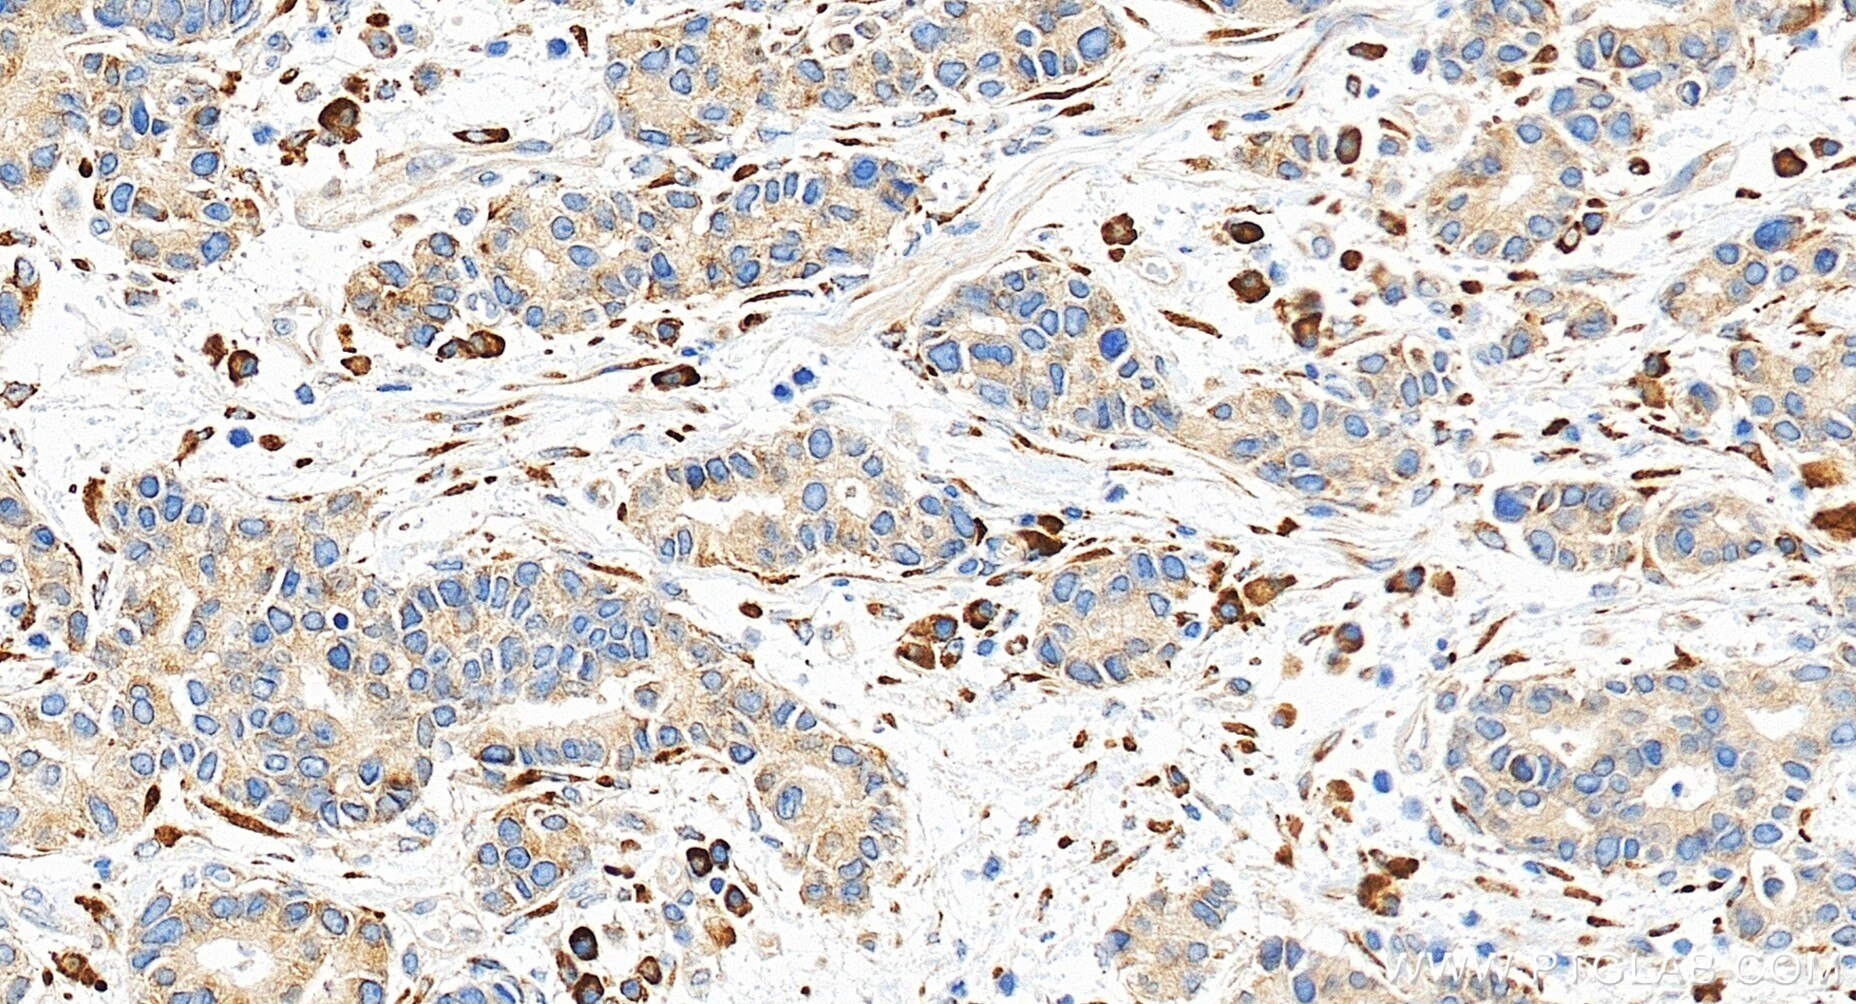
Immunohistochemical analysis of paraffin-embedded human stomach cancer tissue slide using 85374-1-RR (P4HA3 antibody) at dilution of 1:1000 (under 20x lens). Heat mediated antigen retrieval with Tris-EDTA buffer (pH 9.0). This data was developed using the same antibody clone with 85374-1-PBS in a different storage buffer formulation. Immunohistochemistry (IHC) staining of human stomach cancer tissue using P4HA3 Recombinant monoclonal antibody (85374-1-RR)

Product Information
85374-1-PBS targets P4HA3 in WB, IHC, IF/ICC, Indirect ELISA applications and shows reactivity with human samples.
| Tested Reactivity | human |
| Host / Isotype | Rabbit / IgG |
| Class | Recombinant |
| Type | Antibody |
| Immunogen |
CatNo: Ag19716 Product name: Recombinant human P4HA3 protein Source: e coli.-derived, PGEX-4T Tag: GST Domain: 28-256 aa of BC126170 Sequence: GDTFSALTSVARALAPERRLLGLLRRYLRGEEARLRDLTRFYDKVLSLHEDSTTPVANPLLAFTLIKRLQSDWRNVVHSLEASENIRALKDGYEKVEQDLPAFEDLEGAARALMRLQDVYMLNVKGLARGVFQRVTGSAITDLYSPKRLFSLTGDDCFQVGKVAYDMGDYYHAIPWLEEAVSLFRGSYGEWKTEDEASLEDALDHLAFAYFRAGNVSCALSLSREFLLY Predict reactive species |
| Full Name | prolyl 4-hydroxylase, alpha polypeptide III |
| Calculated Molecular Weight | 544 aa, 61 kDa |
| Observed Molecular Weight | 61 kDa |
| GenBank Accession Number | BC126170 |
| Gene Symbol | P4HA3 |
| Gene ID (NCBI) | 283208 |
| RRID | AB_3744171 |
| Conjugate | Unconjugated |
| Form | Liquid |
| Purification Method | Protein A purification |
| UNIPROT ID | Q7Z4N8 |
| Storage Buffer | PBS only, pH 7.3. |
| Storage Conditions | Store at -80°C. |
Background Information
Collagen prolyl 4-hydroxylases catalyze the hydroxylation of proline in x-pro-gly triplets in collagens and in proteins with collagen-like sequences. Collagen prolyl 4-hydroxylases are tetramers of 2 alpha subunits, such as P4HA3, and 2 beta subunits(P4HB). P4HA3 has 3 isoforms produced by alternative splicing with the MW of 61 kDa, 29 kDa and 67 kDa.